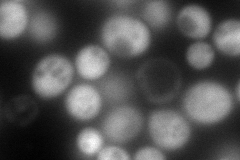
YMR271C
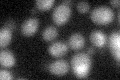
YMR271C
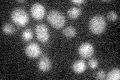
YMR271C

View description
Minor orotate phosphoribosyltransferase (OPRTase) isozyme that catalyzes the fifth enzymatic step in the de novo biosynthesis of pyrimidines, converting orotate into orotidine-5'-phosphate; major OPRTase encoded by URA5
Localization:
Intensity:
Fold change:
Significance:
-
C’ GFP library in SD

below threshold17.2 -
N' NOP1pr-GFP in SD
cytosol272.454 -
N' TEF2pr-mCherry in SD

cytosol510.394 -
N' NATIVEpr-GFP in SD

cytosol32.92 -
N' TEF2pr-VC and Cyto-VN in SD

#N/A0 -
C’ GFP library in SD+DTT
cytosol18.761.09No -
C’ GFP library in SD+H2O2

cytosol14.710.85No -
C’ GFP library in Starvation Media
cytosol21.941.27No -
C’ GFP library on the background of Pup2-DaMP

below threshold -
C’ GFP library on the background of CCT mutant

below threshold16.65990.968072No
